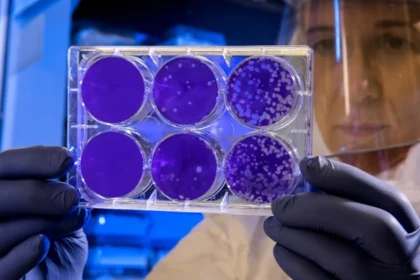
Crisis or Just a Risk Evaluating

The CEO Views
Crisis or Just a Risk? Evaluating U.S. Meningitis Preparedness After the UK Outbreak
Since the Centers for Disease Control and Prevention (CDC) recommended that all adolescents be vaccinated against the meningococcal disease back…
Discover The Alternative Paths to Success in America
As we navigate a world of continuous change and disruption, the route to success is no longer going to college,…
Physical Therapy Redefined: Top Trends to Watch For
When someone says they’re enrolled in a physical therapy program, what do you think of? Many people may think of…
Employee Performance Monitoring Redefined: 10 Smarter Ways
As the modern workplace environment continues to evolve, organizational employees are being prioritized to achieve optimal success. Employee productivity, being…
A Tale of Inspiration Personal Transformation Stories in the USA
Invoking our conscience is not something that an individual does with a blink of an eye. Self-awakening is a continuous…
Is Your Logistics Team Leaving Money on the Table With Outdated LTL Agreements?
Less-than-truckload (LTL) shipping should be cost-effective. However, vague and outdated contracts can lead to budget instability and billing errors. Unless…
How Online Brands Can Use Custom Apparel to Strengthen Identity
In a digital world where attention spans are short and competition is fierce, custom apparel gives online brands something powerful:…
Unforgettable NCAA Men’s Basketball Performances of 2026
The 2026 National Collegiate Athletic Association (NCAA) conducted its 87th Men’s basketball tournament on March 17, 2026, marking the win…
Latest Studies Show that Q&A Content Drives 36% of Conversions
The latest statistics show that people no longer browse the internet. They search with intent, and they also expect immediate…
Why 1031 Exchange Properties Are a Smart Strategy
Real estate investment relies on strategic planning and sound judgment. Property owners are always on the hunt for wealth-building strategies…
How Insurance Adjusters Evaluate Injury Claims in Boise
When you file an insurance claim after an accident in Boise, your file is assigned to a claims adjuster whose…
Spring Dating Season Has Arrived — Here’s How To Prepare
Spring tends to shift how people approach dating. As the weather improves and schedules open up, many people feel more…
How to Choose the Right Forklift for the Size of Your Business
Whether you're running a small warehouse or managing a large-scale distribution center, choosing the right forklift is one of the…
The Hidden Cost of Trying to Handle an Injury Claim Alone in Atlanta
When you sustain an injury in Atlanta due to someone else's negligence, the immediate pressure to resolve your financial losses…
From Photos to Reels: How Instagram Likes Influence What We See
Open Instagram for a moment and start scrolling. Just a few seconds is enough. A photo shows up. Then a…